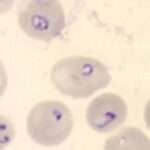
Babesiosis

La fotodermatosis es una condición cutánea que se caracteriza por una reacción anormal de la piel ante la exposición a la luz solar o a la radiación ultravioleta (UV). Se clasifica en cuatro grupos principales, cada uno con diferentes causas y mecanismos subyacentes.
- Fotodermatosis primarias: Estas son fotodermatosis de causa idiopática, lo que significa que su origen no está completamente comprendido. Se cree que son mediadas inmunológicamente, lo que implica una respuesta inmune anormal a la exposición a la luz solar. Estas reacciones pueden ser agudas o crónicas y se caracterizan por eritema (enrojecimiento), vesículas y picor en las áreas expuestas a la luz solar. Algunos ejemplos de fotodermatosis primarias incluyen la erupción polimorfa a luz solar y la urticaria solar.
- Fotodermatosis inducidas por fármacos o químicos: Algunas sustancias químicas, incluidos ciertos medicamentos y productos químicos, pueden desencadenar una reacción de fotosensibilidad en la piel. Estos compuestos pueden interactuar con la luz solar o la radiación UV, lo que resulta en una reacción cutánea anormal. Las áreas expuestas a la luz solar pueden desarrollar erupciones, ampollas, enrojecimiento y picor. Algunos ejemplos de medicamentos asociados con la fotodermatosis incluyen ciertos antibióticos, diuréticos, antiinflamatorios no esteroides (AINEs) y agentes quimioterapéuticos.
- Dermatosis que empeoran con la exposición a la luz ultravioleta: Algunas afecciones dermatológicas existentes pueden agravarse o empeorar debido a la exposición a la luz solar o a la radiación UV. Estas condiciones pueden incluir el lupus eritematoso sistémico, el lupus eritematoso discoide, el vitiligo, la rosácea y el acné. En estos casos, la radiación UV puede desencadenar o exacerbar la inflamación y los síntomas cutáneos asociados con estas enfermedades.
- Enfermedades genéticas con mutaciones predisponentes a la fotodermatosis: Algunas enfermedades genéticas están asociadas con una mayor susceptibilidad a la fotodermatosis. Estas afecciones pueden afectar la capacidad de la piel para reparar el daño inducido por la radiación UV o pueden alterar la respuesta inmune ante la exposición a la luz solar. Ejemplos de enfermedades genéticas relacionadas con la fotodermatosis incluyen el xeroderma pigmentoso y el síndrome de Cockayne.

Síguenos en X: @el_homomedicus y @enarm_intensivo Síguenos en instagram: homomedicus y en Treads.net como: Homomedicus